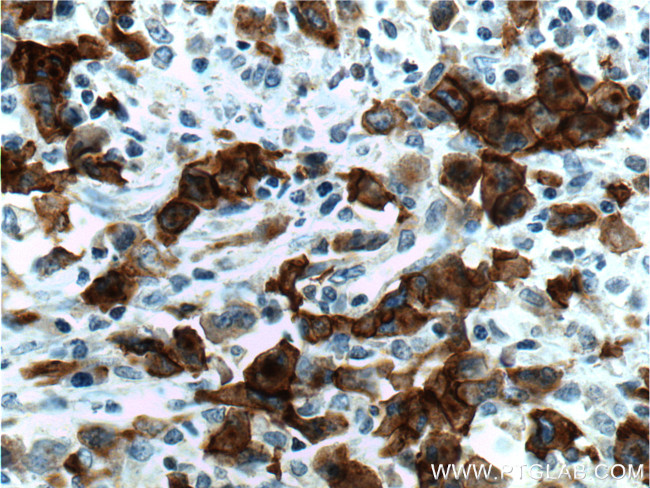
CD30 Antibody in Immunohistochemistry (Paraffin) (IHC (P))

Search
Proteintech
CD30 Polyclonal Antibody
{{$productOrderCtrl.translations['antibody.pdp.commerceCard.promotion.promotions']}}
{{$productOrderCtrl.translations['antibody.pdp.commerceCard.promotion.viewpromo']}}
{{$productOrderCtrl.translations['antibody.pdp.commerceCard.promotion.promocode']}}: {{promo.promoCode}} {{promo.promoTitle}} {{promo.promoDescription}}. {{$productOrderCtrl.translations['antibody.pdp.commerceCard.promotion.learnmore']}}
产品信息
55132-1-AP
种属反应
宿主/亚型
分类
类型
抗原
偶联物
形式
浓度
规格
纯化类型
保存液
内含物
保存条件
运输条件
靶标信息
CD30 (Ki-1, TNF Receptor Superfamily Member 8) is a type I transmembrane glycoprotein of the TNF receptor superfamily. CD30 was originally identified as a cell surface antigen of Hodgkins and Reed-Sternberg cells using monoclonal antibody Ki-1. The ligand for CD30 is CD30L (CD153). The binding of CD30 to CD30L mediates pleiotropic effects including cell proliferation, activation, differentiation, and apoptotic cell death. CD30 has a critical role in the pathophysiology of Hodgkin's disease and other CD30+ lymphomas. CD30 acts as a costimulatory molecule in thymic negative selection. In addition to its expression on Hodgkin's and Reed-Sternberg cells, CD30 is also found in some non-Hodgkin's lymphomas (including Burkitt's lymphomas), virus-infected T and B cells, and on normal T and B cells after activation. In T cells, CD30 expression is present on a subset of T cells that produce Th2-type cytokines and on CD4+/CD8+ thymocytes that co-express CD45RO and the IL4 receptor. Soluble form of CD30 (sCD30) serves as a marker reflecting Th2 immune response. TRAF2 and TRAF5 can interact with this receptor, and mediate the signal transduction that leads to the activation of NF-kappaB. CD30 is a positive regulator of apoptosis, and has been shown to limit the proliferative potential of autoreactive CD8 effector T cells and protect the body against autoimmunity. Two alternatively spliced transcript variants of this gene encoding distinct isoforms have been reported. CD30 is expressed by mononuclear cells in Hodgkin's lymphoma, Reed Sternberg cells and most Anaplastic Large Cell Lymphomas (ALCL). CD30 is also expressed by embryonal carcinomas.
仅用于科研。不用于诊断过程。未经明确授权不得转售。
篇参考文献 (0)
生物信息学
蛋白别名: Ber-H2; CD30; CD30 antigen; CD30 molecule; CD30L receptor; cytokine receptor CD30; Ki-1 antigen; Lymphocyte activation antigen CD30; sCD30; soluble CD30; Tumor necrosis factor receptor superfamily member 8
基因别名: CD30; D1S166E; Ki-1; TNFRSF8
UniProt ID: (Human) P28908
Entrez Gene ID: (Human) 943